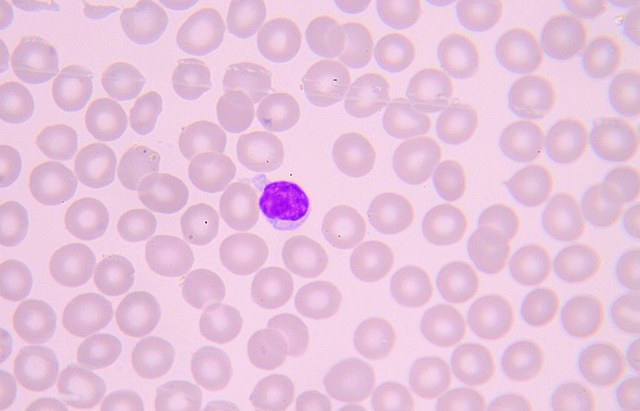
Leucocitos

-
Describió una peste en Atenas, donde los que ya se habían recuperado de la enfermedad, no la contraían una segunda vez.
-
Lady Mary Wortley Montagu, observó los efectos positivos de la variolización sobre la población turca nativa, practicada en sus hijos.
-
Inoculó a un niño de 8 años con líquido de una pústula de viruela vacuna y luego lo infectó con viruela, sin presentar la enfermedad.
-
Louis Pasteur vacunó ovejas con la bacteria del ántrax (Bacillus anthracis), y estas no murieron al ser expuestas a la enfermedad.
-
Inoculó a Josheph Meister, un niño mordido repetidas veces por un perro rabioso, con virus de la rabia atenuado, y el niño vivió.
-
Investigación de Emil von Behring y Shibasaburo Kitasato, proporcionó la primera información del mecanismo de inmunidad.
-
Nobel en Fisiología/Medicina, demostrando que el suero de animales inmunizados con difteria, transfieren inmunidad.
-
Observó anafilaxia al intentar inmunizar a perros contra toxinas de medusa.
-
Robert Kock, descubrimiento del bacilo de Koch y del mecanismo de respuesta inmune contra el microorganismo (Mycobacterium tuberculosis).
-
Observó que fagocitos infieren microorganismos y material extraño. Que luego se conocieron como monocitos y neutrófilos.
-
Descubrimiento de la bacteriólisis mediada por complemento, por Jules Bordet.
-
Un avance importante en el tratamiento de enfermedades infecciosas se logró cuando se introdujeron los primeros antibióticos.
-
Descubrimiento de grupos sanguíneos ABO, útil para transfusiones de sangre
-
Se creyó que cada actividad inmune dependía de una fracción de suero: Globulina gamma (inmunoglobulina).
-
Logró conferir inmunidad contra la tuberculosis al transferir leucocitos entre cobayos.
-
Se indicó la existencia de 2 tipos de linfocitos: Linfocitos T (del timo) y linfocitos B (de la Bolsa de Fabricio en médula ósea)
-
Se identificó al linfocito como el tipo de célula del cual dependen las inmunidades celular y humoral
-
Descubrimiento de tolerancia inmunitaria adquirida, por F. Macfarlane Burney y Peter Medawar, que les dio el premio Nobel.
-
Premio Nobel a Rodney R. Porter y Gerald M. Edelman por el descubrimiento de la estructura química de anticuerpos
-
Descubrió el mecanismo que está detrás de la recombinación de ADN que generan receptores de célula B y anticuerpos.
-
Último caso conocido de viruela adquirida naturalmente en Somalia
-
Al erradicarse, terminó la vacunación antivariólica, dejando a más de la mitad de la población mundial suceptible a la enfermedad.
-
Descubrimiento del complejo principal de histocompatibilidad, sobre antígenos tisulares y el rechazo inmunitario de tejidos trasplantados.